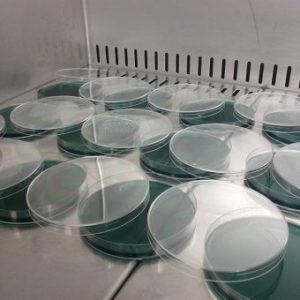

Contenido del curso
Diploma
El curso tiene una duracion de 1 a 3 meses (380 hrs.) y Diploma acreditativo
Objetivos generales sobre el cultivo celular
- Conocer el concepto de quemadura, quemado,…
- Conocer la actuación inicial necesaria en caso de quemaduras y su tratamiento local posterior.
- Concepto,tipos y cobertura cutánea de grandes quemados.
- Saber los diferentes avances genéticos relacionados con este campo y su utilización: cultivos de piel, células madre,…
- Diferenciar los diferentes tipos de injertos cutáneos relevantes y su utilización.
Salidas profesionales del Curso
Hospitales / Clinicas sanitarias en centro de quemadosPrograma
- Introducción.
- Cultivo de piel modificada genéticamente.
- Células madre.
- Tratamiento local de las quemaduras.
- Cobertura de grandes quemados.
- Sustitutivos cutáneos.
- Conclusiones.
- Bibliografía.
Preguntas frecuentes
¿Cómo se realiza la compra de un curso?
Puedes comprar un curso directamente desde nuestra tienda online. Simplemente elige el curso que te interesa, añádelo al carrito y sigue los pasos del proceso de compra hasta realizar el pago.
¿Cuáles son las formas de pago disponibles?
Aceptamos pagos con tarjeta de crédito y débito (Visa, Mastercard, etc.)y PayPal. Todos los pagos son seguros y están encriptados.
¿Cuándo recibiré el curso tras comprarlo?
Una vez confirmado el pago, recibirás un email con el acceso inmediato al contenido del curso en formato digital (PDF o acceso online, según el curso).
¿Necesito estar conectado a internet para hacer el curso?
No necesariamente. Muchos de nuestros cursos se entregan en formato PDF descargable, por lo que puedes estudiarlos sin conexión. Algunos cursos ofrecen contenido complementario online.
¿Cuánto tiempo tengo para completar el curso?
No hay límite de tiempo. Puedes realizarlo a tu ritmo, cuando mejor te venga.
¿Entregáis certificado al finalizar el curso?
Sí. Todos nuestros cursos incluyen certificado acreditativo, que recibirás por email al completar el curso.
¿El certificado tiene validez oficial?
No son certificados oficiales del Estado, pero están avalados por varias universidades como la UJI y Montemorelos, así como asociaciones nacionales: Asoenfermería y Asodeindo, y son válidos como formación complementaria en muchas oposiciones, bolsas de trabajo o procesos de selección.
¿Puedo pedir factura?
Sí. Durante el proceso de compra puedes introducir tus datos fiscales para recibir automáticamente la factura.

